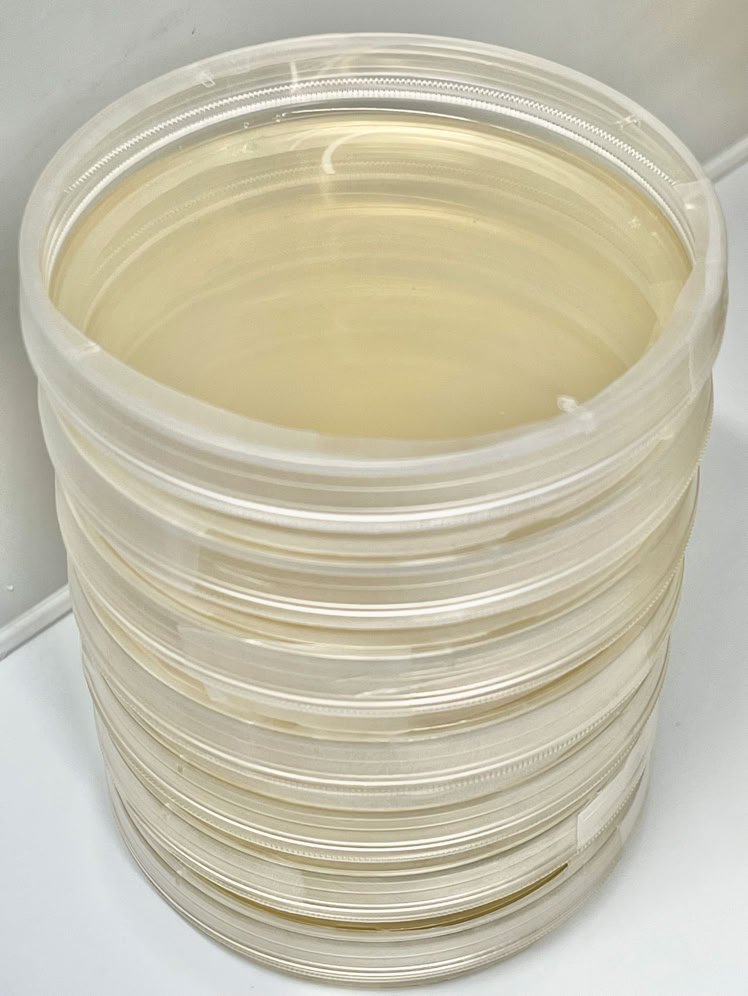
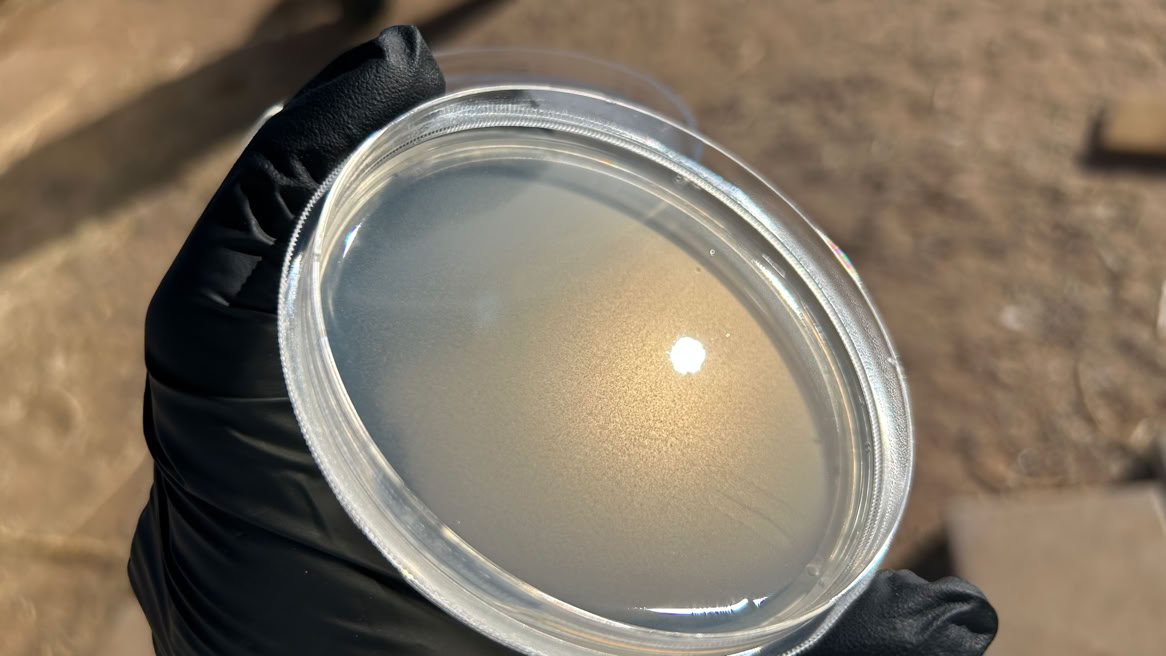

ALL PRODUCTS PREPARED IN ISO 6 CONTROLLED ENVIRONMENT

SAF
CLASSIC ORGANIC NUTRIENT AGAR POWDER for 1L FLUID

TAGAR ORGANIC NUTRIENT AGAR POWDER for 1L FLUID

TGELUXE HYDROGEL POWDER for 1L FLUID

Sterilized Modified Melon Norkrans
10 PACK
Specimen isolation growth medium.
Choose with or without Gentamicin.
Gamma Sterilized Petri Dish Sample Filled With your Choice of Sterilized Proprietary Organic Agar Formula
Single Dish Samples, shipped daily, weekdays only.

Gamma Sterilized Petri Dishes Filled With Sun Again Farm Proprietary Organic Agar Formula 10 PACK
TAGAR™
Proprietary Organic Formula Mycology Growth Medium
10 PACK

500 Gamma Sterilized Petri Dishes Filled With TAGAR™ Sun Again Farm Proprietary Organic Agar Formula

500 Gamma Sterilized Petri Dishes Filled With SAF CLASSIC Sun Again Farm Proprietary Organic Agar Formula
SUN AGAIN FARM LLC.
200 S Curtis Ave. #706
WILLCOX, AZ 85643-2144
niko@sunagainfarm.com
(520) 425-4912
TEXT PREFERED, CALLS ARE SCREENED